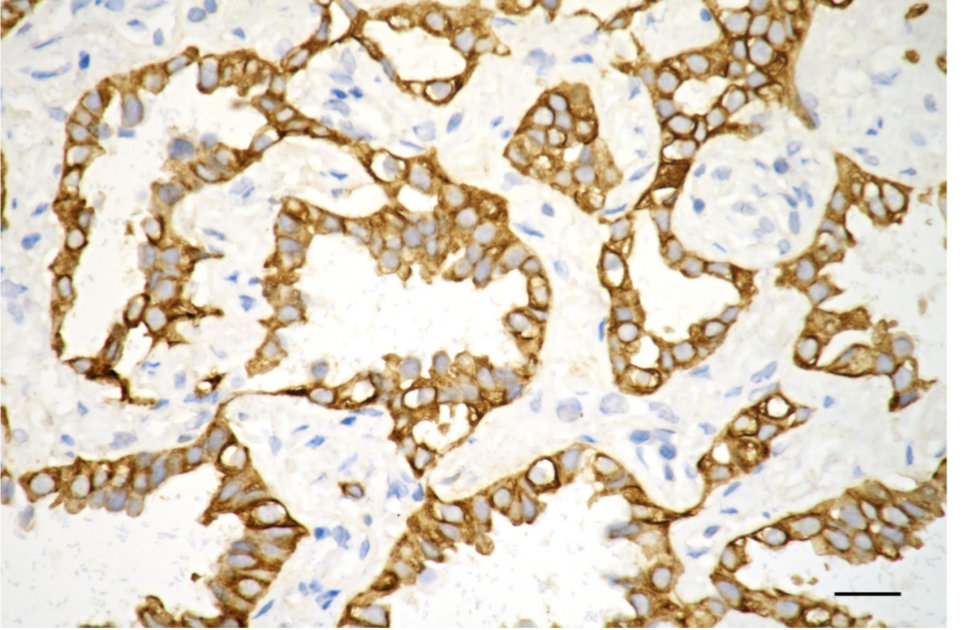

-
中文名稱:KRT7 Recombinant Monoclonal Antibody
-
貨號:CSB-RA976262A0HU
-
規格:¥1320
-
圖片:
-
Flow cytometric analysis of Keratin 7 expression in HepG2 cells using Keratin 7 antibody. Green, isotype control; red, Keratin 7.
-
Immunocytochemical staining of HepG2 cells with Keratin 7 antibody. Nuclei were stained blue with DAPI; Keratin 7 was stained magenta with Alexa Fluor? 647. Images were taken using Leica stellaris 5. Protein abundance based on laser Intensity and smart gain: High. Scale bar, 20 μm.
-
Immunohistochemistry was performed on paraffin-embedded human lung adenocarcinoma using keratin 7 antibody. Antigen retrieval was done in sodium citrate buffer (pH 6.0). DAB was used for detection, with hematoxylin counterstaining. Images were acquired using a Nikon Ci-L Plus microscope (40× objective). Scale bar: 25 μm.
-
Western blotting analysis using keratin 7 antibody. Total cell lysates (30 μg) from various cell lines were loaded and separated by SDS-PAGE. The blot was incubated with keratin 7 antibody and HRP-conjugated goat anti-rabbit secondary antibody respectively.
-
-
其他:
產品詳情
-
Uniprot No.:
-
基因名:KRT7
-
別名:KRT7; Keratin?7; CK-7; SCL; K7; Keratin, Type II Cytoskeletal?7; Sarcolectin; K2C7; CK7; Keratin, 55K Type II Cytoskeletal; Type-II?Keratin?Kb7; Keratin?7, Type II; Cytokeratin?7; Keratin, Simple Epithelial Type I, K7; Type II Mesothelial?Keratin?K7; Cytokeratin-7; Keratin-7
-
反應種屬:Human
-
免疫原:A synthesized peptide derived from Human KRT7 protein
-
免疫原種屬:Homo sapiens (Human)
-
標記方式:Non-conjugated
-
克隆類型:Monoclonal
-
抗體亞型:Rabbit IgG
-
純化方式:Affinity-chromatography
-
克隆號:10A5
-
濃度:It differs from different batches. Please contact us to confirm it.
-
保存緩沖液:Rabbit IgG in PBS (pH 7.4) containing 50% glycerol, and 0.02% sodium azide.
-
產品提供形式:Liquid
-
應用范圍:ELISA, WB, FC, ICC, IHC
-
推薦稀釋比:
Application Recommended Dilution WB 1:2000-1:10000 FC 1:200-1:2000 ICC 1:100-1:1000 IHC 1:100-1:200 -
Protocols:
-
儲存條件:Upon receipt, store at -20°C or -80°C. Avoid repeated freeze.
-
貨期:Basically, we can dispatch the products out in 1-3 working days after receiving your orders. Delivery time maybe differs from different purchasing way or location, please kindly consult your local distributors for specific delivery time.
-
用途:For Research Use Only. Not for use in diagnostic or therapeutic procedures.
相關產品
靶點詳情
-
功能:Blocks interferon-dependent interphase and stimulates DNA synthesis in cells. Involved in the translational regulation of the human papillomavirus type 16 E7 mRNA (HPV16 E7).
-
基因功能參考文獻:
- Data indicate that de novo expression of KRT7 and KRT19 resulting in altered plasticity and stem cell characteristics of epithelial cells might be a crucial factor in increasing the risk of tumor development in end-stage kidneys. PMID: 30194170
- High expression of CK-7 is associated with intrahepatic cholangiocarcinoma. PMID: 29513894
- Positive expression of CK7 associated with pathological features of lymph node metastasis and T stage may be independent clinical parameters for poor prognosis of patients with lung cancer. PMID: 28827446
- Research show that circulating CK7 mRNA positive cells were found in patients with bladder urothelial cancer of varying stages, and the detection rates increased with stage predicting worse clinical scenario. PMID: 28024950
- CK7/ HPV-L1 expression, and the presence of koilocytosis can be used for prognostication in patients with cervical low-grade squamous intraepithelial lesions. PMID: 28554573
- KRT7-AS formed an RNA-RNA hybrid with KRT7 and controlled KRT7 expression at both the mRNA and the post-transcriptional levels. forced overexpression of the KRT7-overlapping region (OL) of KRT7-AS (but not its non-KRT7-OL portions) increased keratin 7 protein levels in cells. Finally, forced overexpression of full-length KRT7-AS or OL KRT7-AS (but not its non-KRT7-OL regions) promoted GC cell proliferation PMID: 26876208
- These data support the theory that CK7 staining may inform risk stratification for low-grade squamous intraepithelial cervical lesions (CIN1). PMID: 27680604
- the status of K7 expression in metastatic lymph nodes from colorectal carcinoma is a poor prognostic factor PMID: 28155971
- Mismatch repair (MMR) defects influence the expression of clinically important biomarkers for endometrioid-type endometrial carcinoma as decreased cytokeratin 7 expression is more commonly associated with MMR deficiency. PMID: 25851713
- Ischemic parenchymal changes are characterized by hepatocyte K7 immunoexpression PMID: 26887669
- Survival analysis showed that the non-small cell lung carcinoma patients with enhanced expression of CK7, ELF3, EGFR, and EphB4 mRNA in peripheral blood leukocytes had poorer disease-free survival and overall survival than those without. PMID: 27827952
- Keratin 34betaE12/K7 expression is a prognostic parameter in resected early stage NSCLC that allows identification of high-risk NSCLC patients with poor cancer-specific and overall survival. PMID: 26057535
- K7 expression was also detected in 72 of 75 triple-negative carcinoma cases PMID: 26670478
- CK7, TTF-1 and napsin A are predominantly expressed in primary lung adenocarcinoma patients, with CDX-2 being inconsistently expressed. PMID: 26469326
- CK7 staining was notably heterogeneous, with 14.5% of all cases demonstrating PMID: 22748158
- Data show that cytokeratin-7 (KRT7) mRNA expression serves as a sensitive approach for the molecular detection of KRT7-positive circulating tumour cells (CTCs)-resembling A549 cells in peripheral whole blood. PMID: 26306784
- Cytokeratin 7 positivity in cervical low-grade squamous intraepithelial lesion is a marker for risk of progression to a high-grade lesion. PMID: 26551618
- Immunostaining for CK7 and epithelial membrane antigen can be used to differentiate interlobular bile ducts from ductular proliferation in patients with cholestasis. PMID: 26366614
- Epithelial-mesenchymal transition-related proteins CK-7 and alpha-SMA colocalized to the intrahepatic biliary epithelial cells in patients with biliary atresia. PMID: 25406900
- The immunofluorescent staining pattern of Wnt1 and CK7 as well as Wnt1 and CK13 was consistent with IHC results. Thus, in pleomorphic adenoma, Wnt is involved in tumor cell differentiation of peripheral columnar cells forming solid nests PMID: 25076852
- The present study confirmed that CK14, but not CK20 or CK7, is expressed in urothelial carcinoma with squamous differentiation and squamous cell carcinoma of the urinary bladder. PMID: 25643514
- Our results suggested that a combination of CK7 and TP53 immunohistochemistry may be helpful in diagnosing inflammatory bowel disease-associated dysplasia in difficult cases. PMID: 23887291
- BRAF-mutated microsatellite stable colorectal carcinoma often displays reduced CDX2 and increased CK7 expression PMID: 24908142
- Loss of cytokeratin 7 is associated with reduced response to concommitant radiochemotherapy for locally advanced cervical cancer. PMID: 24403459
- CK7 and Cam 5.2 expression may occur in SCC. A panel including Ber-Ep4 is advisable for immunohistochemical differentiation of EPD from SCC. PMID: 23590728
- Of the cases of clear cell renal carcinoma there was immunoreactivity for alpha-methylacyl-CoA racemase and strong diffuse immuno-positivity for cytokeratin. PMID: 23434146
- CK7 + centrilobular hepatocytes occur relatively frequently in non-neoplastic liver disease, associated with centrilobular scarring and CK7-positive periportal hepatocytes, and appear to be a non-specific phenomenon of underlying disease. PMID: 22716237
- Heterogeneity of cytokeratin 7 expression in pagetoid Bowen's disease. PMID: 22390404
- Pouch/peripouch and UC-associated adenocarcinoma had a comparable positive rate for CK7, CK20, and CDX2 by immunohistochemistry. PMID: 22895272
- High Cytokeratin-7 is associated with esophageal squamous cell carcinoma. PMID: 22203179
- Both the CK7-/CK20+ phenotype and expression of the antibody CDX2 are highly specific and sensitive markers of colorectal origin. PMID: 22268990
- This is the first reported study of the relationship between CK20/CK7 immunophenotype, BRAF mutations and microsatellite status in colorectal carcinomas PMID: 22361037
- None of the Wilms' tumors-associated lesions were positive for KRT7, but 69-80% of lesions associated with pRCpapillary renal cell tumors and mucinous tubular and spindle cell carcinomas were positive for KRT7. PMID: 22382985
- The expressions of CK7 and CK20 in nasal polyps were analyzed. PMID: 22119824
- Aberrant expression of K7 in budding cancer cells represents a modification of the epithelial phenotype ('epithelial-epithelial transition': EET) which may be linked to gains in motility and invasive potential. PMID: 21884201
- CK-7 expression grades correlated positively with histological stages of primary biliary cirrhosis (r=0.639, P<0.000) and negatively with granulomas (r=-0.432, P<0.0001; OR=0.173, P=0.0011). PMID: 21681009
- Our results reveal that menopause influences the adipose tissue expression of many genes, especially of neurexin 3, metallothionein 1E, and keratyn 7, which are associated with the alteration of several key biological processes. PMID: 21358552
- Our results along with the data from the literature indicate that CK7/CK20 expression may be of clinical significance. PMID: 21574103
- Case Report: Primary pulmonary adenocarcinoma with enteric differentiation resembling metastatic colorectal carcinoma, negative for cytokeratin 7. PMID: 20727680
- A considerable number of colorectal carcinomas showed immunoreactivity to CK7. PMID: 21282015
- Hepatocyte CK7 expression is frequently noted in chronic allograft rejection, and it would appear to reflect ductopenia. PMID: 21228364
- Immunohistochemistry for cytokeratins 7 and 19, which mark biliary epithelium, is helpful in the diagnosis of biliary diseases. PMID: 20538416
- Endometrial adenocarcinomas show micro-anatomical variations in Ki67 expression and this is often inversely correlated with CK7 immunoreactivity. PMID: 20557372
- Case Report: CK7+/CK20- Merkel cell carcinoma presenting as inguinal subcutaneous nodules with subsequent epidermotropic metastasis. PMID: 20574624
- the expression of Cytokeratins 7, 8, 18, and 19 may serve as differential diagnostic markers for pulmonary large cell neuroendocrine carcinoma and small cell lung carcinoma PMID: 20398190
- CK7 is a possible marker for colorectal carcinogenesis. PMID: 17715023
- FOXA1 induces not only KRT7 but also LOXL2 in a subset of poor prognostic esophageal squamous cell carcinomas with metastatic lymph nodes PMID: 20043065
- Toker cells and mammmary Paget cells share immunoreactivity to CK7. PMID: 20001343
- Changing pattern of cytokeratin 7 and 20 expression from normal epithelium to intestinal metaplasia of the gastric mucosa and gastroesophageal junction PMID: 11962749
- HPV16 E7 mRNA-cytokeratin 7 binding in squamous cervical cancer SiHa cells occurs through the 6-mer peptide SEQIKA present in human cytokeratin 7 protein PMID: 12072504
顯示更多
收起更多
-
亞細胞定位:Cytoplasm.
-
蛋白家族:Intermediate filament family
-
組織特異性:Expressed in cultured epidermal, bronchial and mesothelial cells but absent in colon, ectocervix and liver. Observed throughout the glandular cells in the junction between stomach and esophagus but is absent in the esophagus.
-
數據庫鏈接:
Most popular with customers
-
-
Phospho-YAP1 (S127) Recombinant Monoclonal Antibody
Applications: ELISA, WB, IHC
Species Reactivity: Human
-
-
-
-
-
-